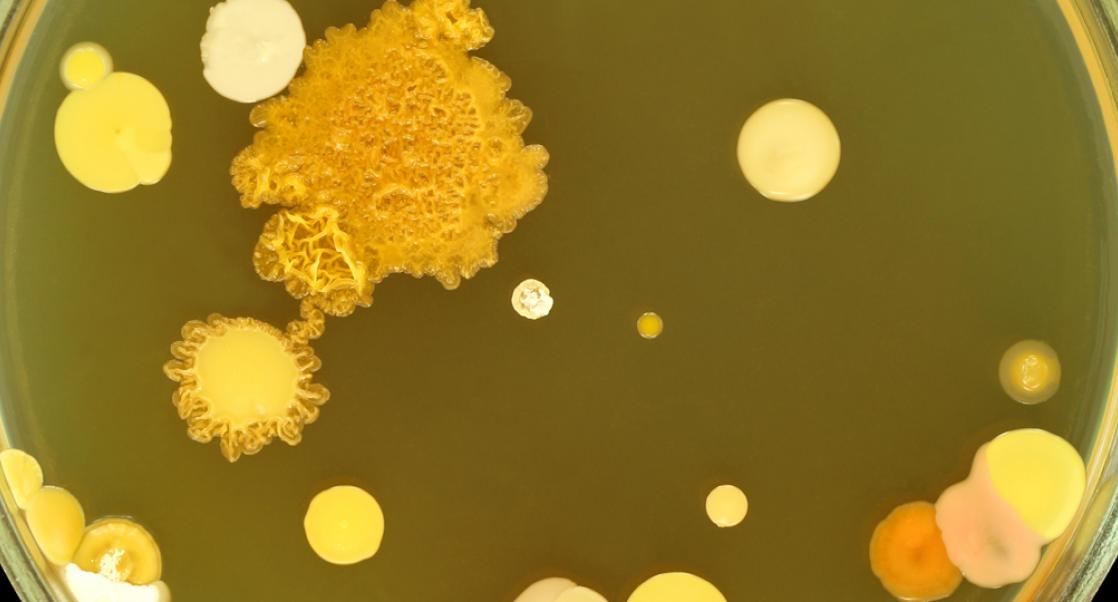
The Microbial Shuffle

Safety Assessment
|
Douglas B. Learn
SOT 2014: Stem Cell Fever
Five years ago, stem cell talks were hard to find at the Society of Toxicology (SOT) meeting that draws over 6,500 scientists from around the world. This year, a Nobel Laureate recognized for nuclear transplantation and cloning, Sir John Bertrand Gurdon, gave the keynote address and stem cell models are one of the central themes of the conference. Douglas Learn, Director of Photobiology, and Shawna Jackman, a Senior Research Scientist in the Photobiology and Cellular Therapeutic Safety group at Charles River Laboratories discuss this evolution during the SOT meeting, which is being held in Phoenix from March 23-26.